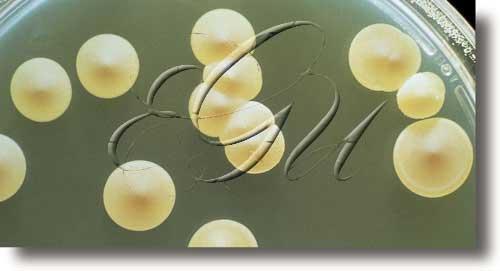

bacteriano -na
bacteriano -na
(< grβακτηρία ‘bastón’)
-
adx
[MICROB]
Relativo ou pertencente ás bacterias.
-
adx
[MICROB]
Causado polas bacterias.
-
transformación bacteriana
[MICROB]
Incorporación de material xenético do medio ao xenoma celular por parte dunha bacteria.